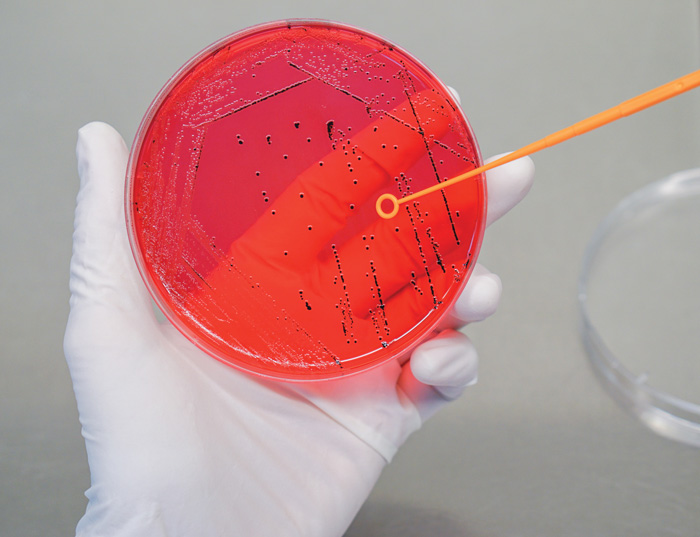
Salmonella in red petri dish

FOOD SAFETY AND QUALITY
Salmonella, Salmonellosis, and Produce

3-D illustration of Salmonella. © Festa/Shutterstock C
Active and passive surveillance data indicate that each year in the United States, an estimated 31 pathogens cause 37.2 million illnesses (9.4 million foodborne), 228,744 hospitalizations (55,961 foodborne), and 2,612 deaths (1,351 foodborne) (Scallan et al. 2011). Norovirus caused 5.5 million (58%) of the illnesses, followed by nontyphoidal Salmonella spp., which caused 1 million (11%) illnesses. In addition, nontyphoidal Salmonella spp. was the leading cause of hospitalization and death (35% and 28%, respectively). Salmonella was estimated to be responsible for $365 million in direct medical costs annually. The microorganism continues to cause more hospitalizations and deaths than any other foodborne microorganism in the United States.
The Centers for Disease Control and Prevention’s (CDC) list of multistate foodborne outbreak investigations for 2020 includes three foodborne outbreaks caused by Salmonella (CDC 2020). The first outbreak involved 48 states and 1,127 people infected with Salmonella Newport. Red onions were the likely source of this outbreak, based on epidemiologic and traceback evidence. The second outbreak involved 17 states and 101 people infected with Salmonella Enteritidis. Peaches were the likely source of this outbreak.
Despite the general perception about the association of animal-based foods as the primary sources of human Salmonella infections, many outbreaks in recent years have been linked to plant-based foods, fresh produce in particular
In the most recent outbreak, the investigation of which is still ongoing, a total of 43 people infected with the outbreak strain of Salmonella Stanley have been reported from 10 states. Dried wood ear mushrooms are the likely source of this outbreak, based on epidemiologic, laboratory, and traceback information. Despite the general perception about the association of animal-based foods as the primary sources of human Salmonella infections, many outbreaks in recent years have been linked to plant-based foods, fresh produce in particular. The three multistate outbreaks caused by Salmonella in 2020 merely highlight that reality, to which many factors might contribute.
Isolation of Salmonella. © Garw Boonan/Shutterstock
Salmonella and Salmonellosis
The genus Salmonella contains two species—Salmonella enterica, with six subspecies and 2,579 serovars, and Salmonella bongori, with 22 serovars. S. enterica serovars Enteritidis, Newport, Stanley, and Typhimurium have been often linked to foodborne illness. Salmonella serotypes can be divided into two main groups: typhoidal and nontyphoidal. Human infections of nontyphoidal Salmonella usually lead to symptoms in 8 to 72 hr after ingestion of the organism. The infectious dose of Salmonella is low—a few cells can make someone ill. Most individuals with Salmonella infection have nonbloody diarrhea, fever, and abdominal cramps, with symptoms usually lasting for five days. The illness is generally self-limiting; most individuals who are sick with a Salmonella infection can successfully recover with extra fluids to replenish water and electrolytes lost because of diarrhea. Some individuals with Salmonella infection develop systemic infections. Salmonella infections can induce chronic illnesses such as reactive arthritis, Reiter’s syndrome, and ankylosing spondylitis after the infection has ended. Newborns, infants, the elderly, and adults with a weakened immune system are more susceptible to Salmonella infections than healthy populations (Matthews et al. 2017).
Preharvest, Harvest, and Postharvest Produce Contamination
Fruits and vegetables contain a variety of microbial contaminants, which may be present at different levels. While produce has been reported to harbor aerobic mesophilic bacteria at levels ranging from 102 to 108 CFU/g, bacterial contamination of fruits has been reported at levels of 105 to 106 CFU/g. There are multiple reasons behind these variations. For example, microorganisms occurring on above-ground plant structures are exposed to dissimilar levels of water, nutrients, and light compared with those underground. Also, substantial differences exist among plants regarding their cultivation and storage following harvest. Regardless of these differences, vegetables mostly harbor Gram-negative bacteria, and fruits harbor mostly yeast (Carlin 2013).

Fresh produce. © kcline/Getty Images
It is well known that produce is susceptible to contamination from microorganisms, including human bacterial pathogens, throughout the entire farm-to-table continuum. Preharvest contamination sources include animal waste, irrigation water, and air. Human bacterial pathogens in animal feces (livestock and wildlife), manures, or fertilizers that are based on sewage sludges can readily contaminate fruit and vegetable production systems.
Water is a significant vector in disease transmission. Large numbers of pathogens in animal waste, including enteric, viral, and bacterial, can be transported various distances via natural or artificial waterways (Bach and Delaquis 2009). Produce is prone to the introduction or dissemination of human pathogens during harvest. Mechanical handling (cutting, trimming, coring, etc.), human handling, and cooling (ice, vacuum) can contribute to contamination during harvest. Postharvest contamination sources include processing (conveying, fluming, shredding, dicing, drying, etc.), mechanical damage, and human handling (Ryser et al. 2009).
The organism continues to cause more hospitalizations and deaths than any other foodborne microorganism in the United States.
Salmonella is well connected to the environments where plants are produced (Barak and Liang 2008; Bell et al. 2012; Gallegos-Robles et al. 2008; Gorski et al. 2011; Hanning et al. 2009; Islam et al. 2004 a, b; Micallef et al. 2012; Patchanee et al. 2010). Salmonella interacts with plants and their associated microbiota (Brandl et al. 2013). Plants may become contaminated with Salmonella by water, especially when surface water is used for irrigation or untreated biological amended soil of animal origin is used (Allende and Monaghan 2015, Jacobsen and Bech 2012, Li et al. 2015, Olaimat and Holley 2012). Surface water and sediment are common sources of Salmonella (Bell et al. 2012, Gorski et al. 2011, Micallef et al. 2012, Strawn et al. 2013). Salmonella can reach plants exposed to aerosols formed by rain (Cevallos-Cevallos et al. 2012). Airborne soil particulates have been shown to serve as vehicles for Salmonella contamination of plants (Kumar et al. 2017). Outbreak-associated Salmonella serotypes have been shown to survive in soil and water for a long time—more than 40 days in soil—and the role of biofilms in abiotic surface attachment has been investigated (Kumar et al. 2018). In investigations dealing with fitness of human enteric pathogens on plants and plant environments, Salmonella has been shown to be a resilient organism under stressful plant cultivation environments with respect to water, temperature, and UV radiation (Brandl 2006, Fatica and Schneider 2011). Plant cultivar, plant growth stage, and Salmonella serovar (e.g., Dublin, Newport, Typhimurium) appear to be important factors regarding survival under adverse environmental conditions (Han and Micallef 2014, Klerks et al. 2007, Zheng et al. 2013).
Salmonella Internalization in Produce
Fruits and vegetables are comprised of natural and fortuitous openings that can serve as ports of entry for penetration of microorganisms. Leaves (stomatas, trichomes, hydathodes), flowers (nectarthodes, floral tubes), fruits (lenticels), and seeds as well as wounds serve as ports of entry prior to harvest. Adverse environmental conditions such as heavy precipitation and wind and frost in fruit orchards, vineyards, and fields can result in bruising and wounding of produce. Mechanical or human interventions during harvest and postharvest can also result in bruising and wounding of produce. Wounds and bruises are a common site of penetration of harvest and postharvest microorganisms. Natural openings such as dead tissues at the blossom end, stem scars, and the calyx are also potential sites for harvest and postharvest microorganisms to penetrate plant tissues. Bacteria lack the ability to directly penetrate plant skin; however, they may be suspended in free water and infiltrate into plant tissues and become internalized (Ryser et al. 2009).
Fruits and vegetables can be contaminated by Salmonella via different means: entry through scar tissues, natural uptake through root systems, and surface contamination of flowering plants followed by internalization during embryogenesis of the plant. Salmonella can internalize through roots as well and has been shown to then locate to the shoots (Barak et al. 2011, Cooley et al. 2003, Klerks et al. 2007).
Salmonella serovars (Klerks et al. 2007, Zheng et al. 2013) and plant cultivars (Han and Micallef 2014) are important factors in Salmonella-plant interactions. A study involving leaf inoculation of tomato plants showed that Salmonella traveled within plants and colonized fruit in absence of any suggestive plant response (e.g., wilting, necrotic lesions, hypersensitive response) (Gu et al. 2011). When produce-associated outbreak strains of Salmonella were introduced to three cultivars of cucumber plants through blossoms or soil, blossoms were identified as an important route for Salmonella internalization at a high percentage (Burris et al. 2020).
Irrigation water is a predictable source of Salmonella contamination in crop production. However, differences exist among research results regarding the ability of Salmonella to colonize the root zone and travel to other tissues in tomato plants (Hintz et al. 2010, Jablasone et al. 2004, Miles et al. 2009, Zheng et al. 2013).
Interventions and Preventive Controls
Recurrent outbreaks of human Salmonella infections from fresh produce as well as recent multistate produce-associated outbreaks emphasize the necessity for implementation of rigorous pathogen control measures by growers, the food industry, and government regulatory agencies.

Salmonella bacteria. ©MichaelTaylor/3d/Shutterstock
Measures such as good agricultural practices (GAPs) are used on the farm to decrease hazards—biological, chemical, physical—that may be associated with fresh produce. GAPs include fertilization of soil with properly composted animal wastes, crop irrigation with appropriately treated effluents, keeping animal intrusion of produce growing fields under control, assuring hygienic handling of produce by on-farm workers, using potable water for produce washes, prevention of cross contamination during postharvest processing, etc. It is apparent that when the microbiological load of crops is reduced at the farm level, the microbiological load of fresh and minimally processed produce can be kept at acceptable levels.
The Food Safety Modern-ization Act (FSMA), with the FSMA Final Rule going into effect in 2015, transformed food safety laws in the United States. Specific sections of FSMA cover human food, animal food, produce, and foreign suppliers. The FSMA Final Rule on Produce Safety addresses standards for growing, harvesting, packing, and holding produce for human consumption with major requirements on agricultural water; biological soil amendments; sprouts; domesticated and wild animals; worker training, health, and hygiene; equipment; tools; and buildings. According to the Final Rule, growers are expected to implement water testing procedures and keep their records on microbial quality of water, which is based on the presence of generic Escherichia coli, a conventional indicator of fecal contamination. Growers may comply with the 90-day interval for crops that are not in contact with the soil after the application of raw manure and the 120-day interval for crops that are in contact with soil. To help prevent the contamination of sprouts, the Final Rule depicts the need for visual examination of fields during the growing season so that the microbial contamination associated with animal intrusion is reduced. The Final Rule also includes requirements to prevent contamination of produce through ill workers as well as through equipment, tools, and buildings.
In recent years, fresh produce has been recognized as a major vehicle for human Salmonella infections. Increased consumer demand for fresh produce and increased global trade of fresh produce have likely contributed to this outcome as well as enhanced foodborne illness surveillance programs and advances in detection and treatment of foodborne illnesses. It’s essential that effective control measures are implemented by government regulatory agencies and the fresh produce industry to keep fresh produce free from Salmonella contamination. After all, fresh fruits and vegetables are an extraordinary dietary source of nutrients for humans and a vital raw material for the food industry.
REFERENCES
Allende, A. and J. Monaghan. 2015. “Irrigation Water Quality for Leafy Crops: A Perspective of Risks and Potential Solutions.” Int. J. Environ. Res. Public Health 12: 7457–7477.
Bach, S. and P. Delaquis. 2009. “The Origin and Spread of Human Pathogens in Fruit Production Systems.” Chpt. 2 in Microbial Safety of Fresh Produce, edited by X. Fan, B. A. Niemira, C. J. Doona, F. E. Feeherry, and R. B. Gravani. Ames, Iowa: IFT Press and Wiley-Blackwell.
Barak, J. D. and A. S. Liang. 2008. “Role of Soil, Crop Debris, and a Plant Pathogen in Salmonella enterica Contamination of Tomato Plants.” PLoS One 3: e1657. doi: 10.1371/journal.pone.0001657.
Barak, J. D., L. C. Kramer, L. Hao. 2011. “Colonization of Tomato Plants by Salmonella enterica Is Cultivar Dependent, and Type 1 Trichomes Are Preferred Colonization Sites.” App. Environ. Microbiol. 77(2): 498–504. doi: 10.1128/AEM.01661-10.
Bell, R., G. Cao, J. Meng, et al. 2012. “Salmonella newport Contamination of Produce: Ecological, Genetic, And Epidemiological Aspects. Salmonella: Classification, Genetics and Disease Outbreaks.” Hauppauge, New York: Nova Science Publishers, Inc.
Brandl, M. T. 2006. “Fitness of Human Enteric Pathogens on Plants and Implications for Food Safety.” Annu. Rev. Phytopathol. 44: 367–392. doi: 10.1146/annurev.phyto.44.070505.143359.
Brandl, M. T., C. E. Cox, M. Teplitski. 2013. “Salmonella Interactions With Plants and Their Associated Microbiota.” Phytopathology 103: 316–325.
Burris, K. P., D. O. Simmons, H. M. Webb, et al. 2020. “Colonization and Internalization of Salmonella enterica and its Prevalence in Cucumber Plants.” Front. Microbiol. 11: 1135. doi: 10.3389/fmicb.2020.01135.
Carlin, F. 2013. “Fruits and Vegetables.” Chpt. 8 in Food Microbiology: Fundamentals and Frontiers, edited by M. P. Doyle and R. L. Buchanan. 4th ed. Washington, DC: ASM Press.
CDC. 2020. “Reports of Selected Salmonella Outbreak Investigations.” https://www.cdc.gov/salmonella/outbreaks.html.
Cevallos-Cevallos, J. M., G. Gu, M. D. Danyluk, et al. 2012. “Salmonella Can Reach Tomato Fruits on Plants Exposed to Aerosols Formed by Rain.” Int. J. Food Microbiol. 158: 140–146. doi: 10.1016/j.ijfoodmicro.2012.07.009.
Cooley, M. B., W. G. Miller, R. E. Mandrell. 2003. “Colonization of Arabidopsis thaliana With Salmonella enterica and Enterohemorrhagic Escherichia coli O157:H7 and Competition by Enterobacter asburiae.” Appl. Environ. Microbiol. 69: 4915–26. doi: 10.1128/aem.69.8.4915-4926.2003.
Fatica, M. K. and K. R. Schneider. 2011. “Salmonella and Produce: Survival in the Plant Environment and Implications in Food Safety.” Virulence 2: 573–579. doi: 10.4161/viru.2.6.17880.
Gallegos-Robles, M. A., A. Morales-Loredo, G. Alvarez-Ojeda, et al. 2008. “Identification of Salmonella Serotypes Isolated From Cantaloupe and Chile Pepper Production Systems in Mexico by PCR-Restriction Fragment Length Polymorphism.” J. Food Prot. 71: 2217–2222. doi: 10.4315/0362-028x-71.11.2217.
Gorski, L., C. T. Parker, A. Liang, et al. 2011. “Prevalence, Distribution, and Diversity of Salmonella enterica in a Major Produce Region of California.” Appl. Environ. Microbiol. 77: 2734–2748. doi: 10.1128/aem.02321-10.
Gu, G., J. Hu, J. M. Cevallos-Cevallos, et al. 2011. “Internal Colonization of Salmonella enterica Serovar Typhimurium in Tomato Plants.” PLoS One 6: e27340. doi: 10.1371/journal.pone.00027340.
Han, S. and S. A. Micallef. 2014. “Salmonella Newport and Typhimurium Colonization of Fruit Differs From Leaves in Various Tomato Cultivars.” J. Food Prot. 77: 1844–1850. doi: 10.4315/0362-028x.jfp-13-562.
Hanning, I. B., J. D. Nutt, S. C. Ricke. 2009. “Salmonellosis Outbreaks in the United States Due to Fresh Produce: Sources and Potential Intervention Measures.” Foodborne Pathog. Dis. 6: 635–648. doi: 10.1089/fpd.2008.0232.
Hintz, L. D., R. R. Boyer, M. A. Ponder, et al. 2010. “Recovery of Salmonella enterica Newport introduced Through Irrigation Water From Tomato (Lycopersicum esculentum) Fruit, Roots, Stems, and Leaves.” Hortscience 45: 675–678. doi: 10.21273/hortsci.45.4.675.
Islam, M., J. Morgan, M. P. Doyle, et al. 2004a. “Fate of Salmonella enterica Serovar Typhimurium on Carrots and Radishes Grown in Fields Treated With Contaminated Manure Composts or Irrigation Water.” Appl. Environ. Microbiol. 70: 2497–2502. doi: 10.1128/aem.70.4.2497-2502.2004.
Islam, M., J. Morgan, M. P. Doyle, et al. 2004b. “Persistence of Salmonella enterica Serovar Typhimurium on Lettuce and Parsley and in Soils on Which They Were Grown in Fields Treated With Contaminated Manure Composts or Irrigation Water.” Foodborne Pathog. Dis. 1: 27–35. doi: 10.1089/153531404772914437.
Jablasone, J., L. Y. Brovko, M. W. Griffiths. 2004. “A Research Note: The Potential for Transfer of Salmonella From Irrigation Water to Tomatoes.” J. Sci. Food Agric. 84: 287–289. doi: 10.1002/jsfa.1646.
Jacobsen, C. S. and T. B. Bech. 2012. “Soil Survival of Salmonella and Transfer to Freshwater and Fresh Produce.” Food Res. Int. 45: 557–66. doi: 10.1016/j.foodres.2011.07.026.
Klerks, M. M., M. van Gent-Pelzer, E. Franz, et al. 2007. “Physiological and Molecular Responses of Lactuca sativa to Colonization by Salmonella enterica Serovar Dublin.” Appl. Environ. Microbiol. 73: 4905–4914. doi: 10.1128/aem.02522-06.
Kumar, G. D., R. C. Williams, H. M. Al Qublan, et al. 2017. “Airborne Soil Particulates as Vehicles for Salmonella Contamination of Tomatoes.” Int. J. Food Microbiol. 243: 90–95. doi: 10.1016/j.ijfoodmicro.2016.12.006.
Kumar, G. D., R. C. Williams, N. Sriranganathan, et al. 2018. “Survival of Tomato Outbreak Associated Salmonella Serotypes in Soil and Water and the Role of Biofilms in Abiotic Surface Attachment.” Foodborne Path Dis. 15: 548–553. doi: 10.1089/fpd.2017.2416.
Li, B., S. A. Jackson, J. Gangiredla, et al. 2015. “Genomic Evidence Reveals Numerous Salmonella enterica Serovar Newport Reintroduction Events in Suwannee Watershed Irrigation Ponds.” Appl. Environ. Microbiol. 81: 8243–8253. doi: 10.1128/aem.02179-15.
Matthews, K. R., K. E. Kniel, T. J. Montville. 2017. Food Microbiology: An Introduction. Washington, DC: ASM Press.
Micallef, S. A., R. E. Rosenberg Goldstein, A. George, et al. 2012. “Occurrence and Antibiotic Resistance of Multiple Salmonella Serotypes Recovered From Water, Sediment and Soil on Mid-Atlantic Tomato Farms.” Environ. Res. 114: 31–39. doi: 10.1016/j.envres.2012.02.005.
Miles, J. M., S. S. Sumner, R. R. Boyer, et al. 2009. “Internalization of Salmonella enterica Serovar Montevideo Into Greenhouse Tomato Plants Through Contaminated Irrigation Water or Seed Stock.” J. Food Prot. 72: 849–52. doi: 10.4315/0362-028x-72.4.849.
Olaimat, A. N. and R. A. Holley. 2012. “Factors Influencing the Microbial Safety of Fresh Produce: A Review.” Food Microbiol. 32: 1–19. doi: 10.1016/j.fm.2012.04.016.
Patchanee, P., B. Molla, N. White, et al. 2010. “Tracking Salmonella Contamination in Various Watersheds and Phenotypic and Genotypic Diversity.” Foodborne Pathog. Dis. 7: 1113–1120. doi: 10.1089/fpd.2010.0572.
Ryser, E. T., J. Hao, Z. Yan. 2009. “Internalization of Pathogens in Produce.” Chpt. 3 in Microbial Safety of Fresh Produce, edited by X. Fan, B. A. Niemira, C. J. Doona, F. E. Feeherry, R. B. Gravani. Ames, IA: IFT Press and Wiley-Blackwell.
Scallan E., R. M. Hoekstra, F. J. Angulo, et al. 2011. “Foodborne Illness Acquired in the United States–Major Pathogens.” Emerging Infect. Dis. 17(1): 7–15.
Strawn, L. K., E. D. Fortes, E. A. Bihn, et al. 2013. “Landscape and Meteorological Factors Affecting Prevalence of Three Food-Borne Pathogens in Fruit and Vegetable Farms.” Appl. Environ. Microbiol. 79: 588–600. doi: 10.1128/aem.02491-12.
Zheng, J., S. Allard, S. Reynolds, et al. 2013. “Colonization and Internalization of Salmonella enterica in Tomato Plants.” Appl. Environ. Microbiol. 79: 2494–2502. doi: 10.1128/aem.03704-12.
Authors
-
Gülhan Ünlü
Categories
-
Food Sciences
-
Food Safety and Defense
-
Pathogens
-
Food Microbiology
-
Food Technology Magazine